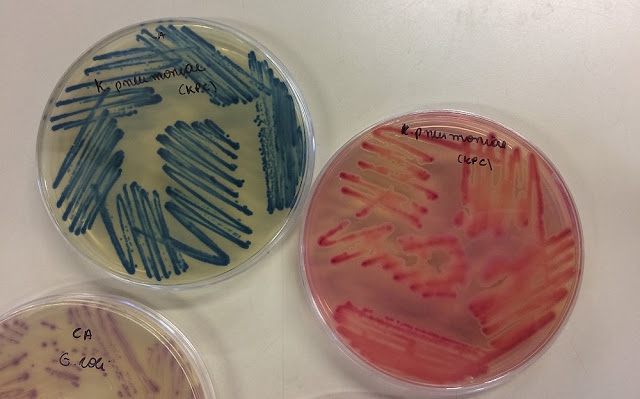

Cada pessoa é mais bactéria do que gente. São 30 trilhões de células humanas para 38 trilhões de bactérias. De tão poderosas, podem desenvolver resistência e parecer indestrutíveis. Então, já não são os hóspedes pacíficos, mas resistentes e letais. São as chamadas superbactérias. Na Bahia, a cada dia de 2018, oito pessoas descobriram abrigar esses micro-organismos, diz a Secretaria de Saúde do Estado da Bahia (Sesab). De 2013 até ano passado, quase triplicaram os casos.
As bactérias estão por todos os lados e não adianta tentar fugir. Podem tirar o combustível da vida do corpo humano, da planta, da água, das raízes, do ar. É difícil saber quando - e como - elas adquirem tanta resistência a ponto de poder matar, em horas, um ser humano até então saudável. Os pesquisadores se apressam em desvendar a jornada das superbactérias.
No caso de Gabriel Dilly, 16 anos, foram necessárias três cirurgias e antibióticos para chegar à vilã. Depois de bater o dedo médio da mão numa porta, algo parecia ir mal. O Raio-X não mostrava nenhuma fratura, mas o dedo ardia, adquirira um tom verde, como se apodrecido. Ninguém sabia que, no corpo de Gabriel, uma bactéria que vive harmoniosamente na pele e mucosas se transformou numa ameaça.
O diagnóstico, que depende de uma análise microbiológica do material onde se alojou a bactéria, mostrou a presença da Staphylococcus aureus, uma das quatro mais resistentes, segundo a Global Antimicrobial Surveillance System (GLASS).
“A gente não entendia o que estava acontecendo. O médico falou que a extensão do pus já tinha atingido a mão”, lembra Mira Dilly, mãe de Gabriel, um garoto de 11 anos em 2014, quando tudo aconteceu.
Monitorados
Na Bahia, são monitorados 13 micro-organismos resistentes. Desde 2010, quando houve aumento na ocorrência da Klebsiella Pneumoniae, a qual se atribui o título de 'A superbactéria', a Sesab tornou obrigatória a notificação das infecções. A Anvisa aprovou, em 2018, o Plano de Ação Nacional de Prevenção e Controle da Resistência aos Antimicrobianos no Âmbito da Saúde Única. A meta é estabelecer uma rede de monitoramento e vigilância dos possíveis casos. Afinal, é um gráfico crescente.
O aumento de infectados por superbactérias nos 552 hospitais baianos mostra o fortalecimento dessas moléculas. Mas, também aponta para uma notificação mais ampla. Pelo menos é assim que os nove profissionais da Comissão de Controle de Infecção Hospitalar (CCIH), em Salvador, interpretam os números. “Essa notificação de 2018 pode não representar só um surto, mas também uma melhora”, explica Fátima Nery, enfermeira e coordenadora do programa.
Como são apenas nove pessoas para acompanham 417 municípios, a subnotificação também é tida como realidade. Ou seja, o número pode ser ainda maior. Em 2016, a Organização Mundial da Saúde (OMS) deu o recado: 700 mil pessoas morriam, anualmente, por infecções bacterianas. E, na ausência de medidas, em 2050, o número poderá crescer a 10 milhões. Resta entender o que está por trás do poder das super bactérias para tentar vencê-la.
Como surgem e para onde vão
Como nascem as superbactérias? A pesquisadora da Universidade Federal do Estado de São Paulo (Unifesp) e infectologista Ana Cristina Gales dedica sua pesquisa a entender a resistência. O uso inadequado de antibióticos é um dos principais problemas. Você já interrompeu o uso de um antibiótico? Então, há riscos de, sem saber, alguma bactéria ter sido fortalecida.
No ano passado, a OMS colocou o Brasil como o 19º maior consumidor de antibióticos numa lista de 65 países. Segundo a Anvisa, existem 126 antibióticos autorizados, enquanto 53 estão em análise em laboratórios brasileiros. Mas, não há como associar os organismos multi-resistentes apenas aos antibióticos. É um fenômeno multifatorial.
"Vai desde o uso inadequado de antibiótico, ao uso do antibiótico no agronegócio. Temos a falta de saneamento básico. Um problema muito sério que é o diagnóstico microbiano”, explicou.
A Agência Nacional de Vigilância Sanitária (Anvisa) libera o uso de antibióticos que promovem o crescimento de aves, por exemplo. Não informou, no entanto, quais e quantos são os compostos autorizados. Depois de comer uma galinha criada à base de antibiótico, você consome, por tabela, a substância. No uso veterinário, o antibiótico é diluído em baixa dosagem no alimento. “Quando eu dou antibiótico, eu dou uma concentração alta para matar, não pequena, pois não mata o suficiente”, diferencia Ana Gales. Como não morrem, ganham resistência.
Resistência
O momento em que uma bactéria torna-se uma bomba relógio depende, também, de cada micro-bioma, nosso conjunto de micro-organismos. "Em algum momento, pode haver desregulação do microbioma. Isso se torna um problema em alguma condição de imunodeficiência", explica o biólogo Pablo Ramos.
Hoje, a resistência à penicilina, o primeiro antibiótico, descoberto em 1929 por Alexander Fleming, chega a 50%. Nos hospitais, o risco de infecção é maior, embora seja perfeitamente possível contrair superbactérias sem pisar os pés numa enfermaria, como aconteceu com Gabriel.
Mas, profissionais de saúde evitam o termo infecção hospitalar, como se o hospital fosse, naturalmente, um agente infeccioso. "[O paciente] está adquirindo essa bactéria, pois está exposto ao tratamento", afirma Ana Gales.
Também começa o controle o uso de antibióticos. No Instituto Couto Maia, referência em doenças infectocontagiosas, três médicos analisam as indicações de antibióticos. Querem, com isso, evitar inadequações na indicação ou na dose. Semanalmente, a equipe visita as salas de Unidade de Terapia Intensiva (UTI) para avaliar os medicamento indicados. Atualmente, não há surto de nenhuma bactéria resistente. A dificuldade é equacionar a necessidade de acompanhar as prescrições com a urgência típica dos casos de infecção.
"Quanto mais tempo um paciente é exposto a um antibiótico, maior risco ele apresenta de desenvolver bactérias multirresistentes", conta Verônica Rocha, coordenadora do serviço de controle de infecção hospitalar da unidade.
Os mistérios da superbactérias ainda estão longe de ser desvendados. Mas, os esforços estão concentrados em impedir o instante em que a bactéria insiste em querer ser maior que o ser humano.
O antibiótico da 'Superbactéria'
Primeiro, a rigidez deixa de ser produzida. Depois, as enzimas da resistência da bactéria são vencidas. Assim funciona o torgena, primeiro antibiótico a combater a KPC, considerada endêmica no Brasil. A bactéria é capaz de causar pneuomia, infecções sanguíneas e generalizadas. Também costuma ser a mais letal dos micro-organismos resistentes.
![]() |
| Mostras da bactéria KPC no laboratório de microbiologia na Unifesp |
Até então, o tratamento da KPC era possível apenas com a união de dois medicamentos. Os profissionais de saúde começaram a perceber, então, que a resistência crescia cada vez mais.
O antibiótico torgena já era licenciado nos Estados Unidos e na União Europeia. Mas, apenas em 2018, após sete estudos clínicas, a Anvisa liberou o uso no Brasil. A esperança é de que o medicamento possa, enfim, por algum obstáculo à superbactéria. "A bactéria estava tranquila, deitando e rolando. A bactéria volta a ser sensível e vamos combater essa infecção", afirmou a diretora-médica da Pfizer, Márjori Dulcine, em encontro promovido para jornalistas em São Paulo.
No Brasil, o alerta da KPC foi ligado em 2009, quando surgem os primeiros casos de infecção pela bactéria, resistente a até 95% dos medicamentos. O aparecimento da KPC nos hospitais, seu ambiente mais comum, seguiu uma rota: da Costa Leste dos Estados Unidos, em 2001, foi para Israel. De Israel, seguiu para China. Daí, espalhou-se pelo mundo.
Na Bahia, de 2013 a 2018, foram 887 registros de infectados pela superbactéria. A secretaria evita falar em mortes causas pela KPC ou outros micro-organismos resistentes, pois o dado pode não representar a realidade clínica.
Também na Bahia, no ano passado, o biólogo Pablo Ramos, ligado à Fiocruz, já havia pesquisado proteínas que poderiam vencer o KPC. O que falta, em sua opinião, é infraestrutura para confirmar, precocemente, um diagnóstico. "Se não temos capacidade de diagnosticar, de nada serve", opina. E o KPC não costuma esperar.
Fonte: Correio / Fotos: Fernanda Lima
Bahia